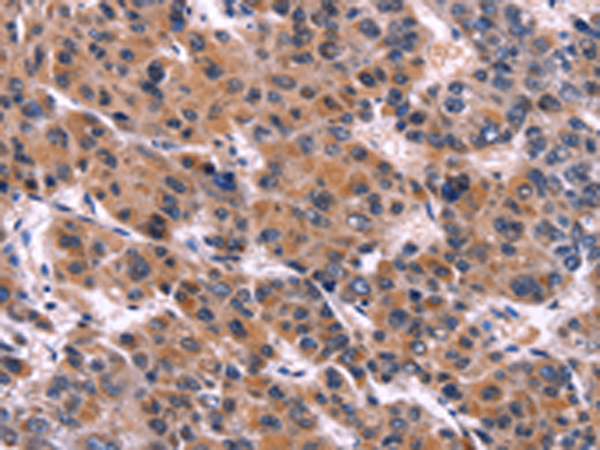

-
分类: 科研抗体货号: P01024别名: MARK; Par1c; Par-1c应用: WB,IHC反应种属: Human, Mouse, Rat
-
分类: 科研抗体货号: P00925别名: ALRP; CARP; C-193; CVARP; MCARP; bA320F15.2应用: WB,IHC反应种属: Human, Mouse, Rat
-
分类: 科研抗体货号: P00976别名: FRSB; PheHB; PheRS; FARSLB; HSPC173应用: WB,IHC反应种属: Human, Mouse
-
分类: 科研抗体货号: P00971别名: HEL-S-182mP应用: WB,IHC反应种属: Human, Mouse, Rat
-
分类: 科研抗体货号: P01086别名: PP14212应用: WB,IHC反应种属: Human, Mouse
-
分类: 科研抗体货号: P01079别名: PLM应用: WB,IHC反应种属: Human, Mouse, Rat
-
分类: 科研抗体货号: P01017别名: PKCE; nPKC-epsilon应用: WB,IHC反应种属: Human, Mouse, Rat
-
分类: 科研抗体货号: P01073别名: GCN2; PVOD2应用: WB,IHC反应种属: Human, Mouse
-
分类: 科研抗体货号: P01014别名: CNM; MTMX; XLMTM应用: WB反应种属: Human, Mouse, Rat
-
分类: 科研抗体货号: P01070别名: M11S1; GPIAP1; RNG105; GPIP137; GRIP137; p137GPI应用: WB,IHC反应种属: Human, Mouse, Rat

鄂公网安备42018502007531号
鄂公网安备42018502007531号

